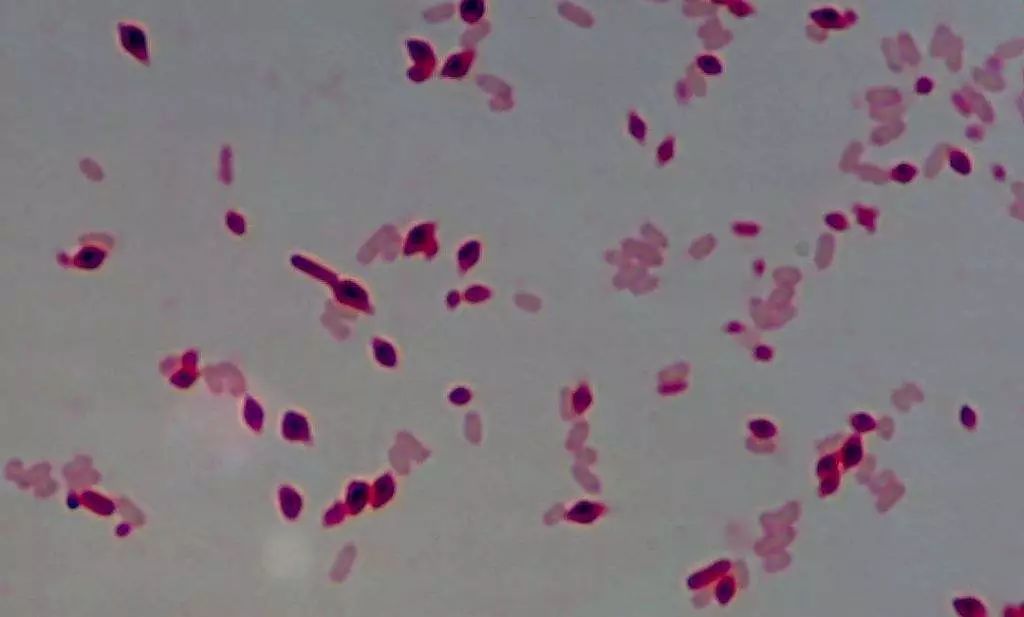
苏云金芽孢杆菌改善土壤微生态环境,促进团粒结构形成,改良土壤质地

侧孢芽孢杆菌

侧孢芽孢杆菌
图片尺寸268x186
侧孢芽孢杆菌
图片尺寸500x666
p> a href="#" data-lemmaid="9492941">芽孢杆菌属 /a>( i>bacillus
图片尺寸1200x794
苏云金芽孢杆菌改善土壤微生态环境,促进团粒结构形成,改良土壤质地
图片尺寸1024x617
侧孢芽孢杆菌农业上的应用
图片尺寸1000x750
水产专用菌-侧孢芽孢杆菌
图片尺寸495x396
侧孢短芽孢杆菌的应用研究进展
图片尺寸500x341
侧孢芽孢杆菌,农业专用芽孢杆菌,农业种植
图片尺寸960x540
芽孢杆菌,迟缓芽孢杆菌,短小芽孢杆菌,凝结芽孢杆菌和侧孢芽孢杆菌等
图片尺寸1332x1000
侧孢芽孢杆菌—水产养殖中的"生态护卫队"
图片尺寸1920x1081
益昊生物供应侧孢芽孢杆菌农业肥料水产养殖专用菌种
图片尺寸2500x2500
汇邦生物侧孢芽孢杆菌价格/侧孢芽孢杆菌厂家
图片尺寸676x608
侧孢芽孢杆菌的多重应用
图片尺寸1062x754
00/kg推荐新品热销销量0侧孢短芽孢杆菌 微生物菌剂 集采专用¥1
图片尺寸1000x1000![[代理] 侧孢芽孢杆菌 南箭 饲料添加剂](https://imgs.wantubizhi.com/img/A1A61BAA66193547F3A6DD7D8EE527E9C644B82A933B094B82320ABAB657D38A9A81560D7596E58F668C6FD33DAC2307F33DD6C29107C4EFD1713606AA4187F6A0680D32BF2AC61D4245C117D0D96962FB3B43FED5AB4284023F888D9C9F29DF)
[代理] 侧孢芽孢杆菌 南箭 饲料添加剂
图片尺寸500x500
侧孢芽孢杆菌的作用机理有哪些?
图片尺寸640x427
其特征在于,所述复合生防菌剂的菌种组分为侧孢短芽孢杆菌-lx12,保藏
图片尺寸844x746
枯草芽孢杆菌的作用及特点枯草芽孢杆菌的使用注意事项
图片尺寸550x340
孢芽孢杆菌询价侧孢芽孢杆菌询价侧孢短芽孢杆菌询价产品详情中文名称
图片尺寸467x449
枯草芽孢杆菌(bacillus thuringiensis),简称bt,是一种常用于生物农药
图片尺寸640x632












![[代理] 侧孢芽孢杆菌 南箭 饲料添加剂](https://imgs.wantubizhi.com/img/A1A61BAA66193547F3A6DD7D8EE527E9C644B82A933B094B82320ABAB657D38A9A81560D7596E58F668C6FD33DAC2307F33DD6C29107C4EFD1713606AA4187F6A0680D32BF2AC61D4245C117D0D96962FB3B43FED5AB4284023F888D9C9F29DF)

![[代理] 侧孢芽孢杆菌 南箭 饲料添加剂](https://file.zhiyao.cn/9786/product/big/201801/p703482001515408952.jpg)




